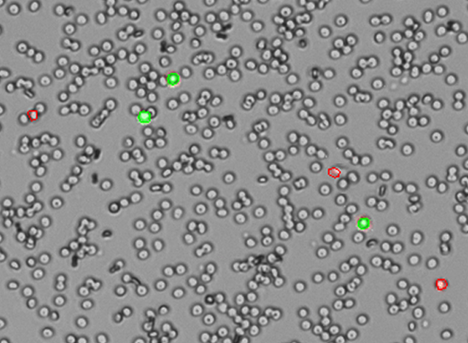
PBMCs counted with AO/PI. Brightfield / Green / Red image overlay for PBMCs counted with AO/PI accurately determine the viability of samples with debris.

Sponsored Content by DeNovix Inc.Reviewed by Louis CastelFeb 4 2024
Trypan Blue is widely used in cell culture laboratories for selectively staining dead cells and tissues. However, the utilization of this dye may pose challenges when accurately evaluating cell counts and viability in certain sample types.
Without implementing additional time-consuming and costly purification steps, primary cell samples are likely to contain debris and non-nucleated cells, which will be difficult to count with trypan blue.
The DeNovix Acridine Orange (AO) / Propidium Iodide (PI) fluorescence viability assay is a user-friendly and more accurate alternative for these sample types.
To discover how to improve cell counting accuracy, download this free eBook.
Download the eBook
Trypan Blue cell counts
Trypan Blue effectively assesses the viability of cell samples with minimal debris. The dye is prevented from entering cells unless the membrane is damaged. In this assay, dead cells are stained a distinctive blue color, while live cells remain transparent.
The Trypan Blue app on the DeNovix CellDrop™ Automated Cell Counter counts live and dead cells, determines cell concentration, and reports viability. The software detects live cells as objects featuring a bright white center enclosed by a sharp dark ring. Stained cells are detected as objects that appear dark in contrast to the background.
Trypan Blue is most effective for samples without debris, such as tissue culture cells trypsinized from a flask or plate. In samples with debris, distinguishing between live cells and debris becomes challenging and subjective. The viability and counts of these samples are frequently overestimated when debris is erroneously included in the count and viability calculation.
AO/PI cell counts
AO is a cell membrane-permeable nucleic acid-binding fluorophore. This dye stains the nuclei of all cells in a sample. PI is a nucleic acid-binding dye that cannot permeate live cells; however, it is well-suited for staining dead, nucleated cells.
The DeNovix AO/PI Viability Assay combines both dyes and is optimized for precise counting and viability evaluation of nucleated cells. The CellDrop FL Automated Cell Counter features an AO/PI app, which utilizes images from the brightfield, green fluorescence, and red fluorescence channels.
Live, nucleated cells exhibit green fluorescence due to AO. Dead, nucleated cells are stained with PI and AO, resulting in red fluorescence due to Förster resonance energy transfer (FRET) quenching of the AO dye by the PI dye. Non-nucleated cells, along with cellular debris, remain unstained.
The AO/PI assay proves highly effective for analyzing nucleated cells in samples containing debris. For example, peripheral blood mononuclear cells (PBMCs) are difficult to quantify with brightfield techniques like the Trypan Blue assay. This is because of the high background of non-nucleated red blood cells, which the dye fails to differentiate.

Figure 1. CHO cells counted with Trypan Blue. Tissue culture cells accurately counted with Trypan Blue. Image Credit: DeNovix Inc.
Figure 2. PBMCs counted with AO/PI. Brightfield / Green / Red image overlays for PBMCs counted with AO/PI accurately determine the viability of samples with debris. Image Credit: DeNovix Inc.
Assessing these samples with AO/PI is easier and more accurate. Within these complex samples, nucleated cells are easily distinguishable by green fluorescence (indicating live cells) or red fluorescence (indicating dead cells) against a background of non-fluorescing cells (shown in Figure 2).
Download the eBook
About DeNovix, Inc.
WELCOME TO DENOVIX
Award-Winning products for Life Science
Our multi-award winning products include the Reviewers’ Choice Life Science Product of the Year and Platinum Seal awarded- DS-11 Series Spectrophotometer / Fluorometer and CellDrop™ Automated Cell Counter. CellDrop is the first instrument of its kind to Count Cells Without Slides. These powerful instruments integrate patented DeNovix technology with easy-to-use software designed by life scientists for life scientists.
Researchers tell us they love the industry leading performance, smart-phone-like operation, and the flexible connectivity of the instruments. When support is needed, the DeNovix team is here to help. DeNovix received the prestigious Life Sciences Customer Service of the Year based on independent reviews posted by scientists worldwide!
CellDrop: Sustainable laboratory product of the year
The CellDrop Automated Cell Counter has been awarded Sustainable Laboratory Product of the Year in the SelectScience® Scientists’ Choice Awards®!
CellDrop’s patented DirectPipette™ technology distinguishes it as the only cell counter to eliminate the need for cell counting slides. This innovation saves millions of single-use plastic slides from use and disposal each year.
Sponsored Content Policy: News-Medical.net publishes articles and related content that may be derived from sources where we have existing commercial relationships, provided such content adds value to the core editorial ethos of News-Medical.Net which is to educate and inform site visitors interested in medical research, science, medical devices and treatments.